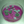
mini profile avatar

Natalia Bellotti
-
ResearcherNational Scientific and Technical Research Council (CONICET)Buenos Aires, Argentina